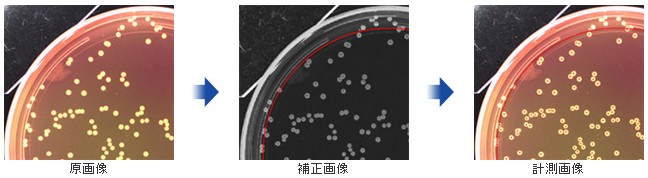

コロニーカウンター
| 製品名 | コロニーカウンター |
|---|
概要
本製品は、瞬時に高精度にコロニー数を計測する、自動計測コロニーカウンターです。
本製品の計測精度は、国内最高峰の評価を頂き、デモにおいても抜群の計測精度と高い
評価を頂いております。開発、生産は全て日本国内で行っており、カスタマイズ、アフター
サービスも万全です。
特長
・独自の照明手法により、高精度な計測を実現しています。
・重なったコロニーを分離計測できます。
・4色の色分離計測ができます。
・計測モードは、簡単モードと標準モードの2種類を装備しています。
・計測するコロニーの大きさ範囲を自由に設定できます。
・保存された画像を、再計測できます。
・コロニーの種類に応じ、4種類のモノクロ変換手法を選択できます。
・プラスカウント、マイナスカウントの手動補正カウントができます。
・表計算ソフトへのデーター転送ができます。
POINT1 輝度ムラの無い照明
独自の照明手法により、計測域において明視野・暗視野状態共に、均一なバックグラウンドを
実現しました。培地とコロニーの微弱な違いであっても、コロニーだけを選択し個数計測が
可能です。
PSF-2000の輝度ムラ(明視野時、暗視野時)
下記は、弊社にてシャーレ内の輝度ムラを確認した結果となります。 PSF-1000タイプは、
コロニーをカウントするにあたり、十分均一な輝度となっており、PSF-2000タイプは、更に
均一な輝度になっております。

PSF-1000の輝度ムラ(明視野時、暗視野時)

POINT2 2種類の計測手法
研究用で、種類の違うコロニーを毎回計測するモードと、品質管理用に同じコロニーを大量に計測
するモードを1つのソフト上で、切り替えて使用できます。
簡単モード画面

ライブ画像を表示した状態で、画像の明るさ、コロニーのみを抽出するしきい値を調整し、コロニーをカウントする最適条件を決める事ができます。種類の違うコロニーを毎回計測する場合に最適です。また、簡単で、感覚的にすぐに操作でき、その時の計測条件も保存・呼び出しが可能です。
使用用途:研究開発に便利。いろいろな培地に対し、条件設定する事無く簡単にカウント可能。
標準モード画面

コロニーの種類により、計測条件を計測前に作成します。同じ種類のコロニーを大量に計測する場合に最適です。簡単モードより、下記の詳細な計測条件設定ができます。
・モノクロ化の方法は4種類より選択
・明るさムラのある培地を平坦にする処理
・円形でないゴミ等を選択外にする処理
・4種類の色によるコロニー分離計測処理
使用用途:検査に便利。同じ培地で複数検体をカウントする。
POINT3 モノクロ化の手法は4種類
コロニーと培地を分離する際、コントラストが強いモノクロ化を選択でききます。(標準モードのみ)
![]() |
![]() |
![]() |
![]() |
![]() |
| 原画 | 単純モノクロ化 | B成分モノクロ化 | G成分モノクロ化 | R成分モノクロ化 |
培地とコロニーのコントラストが強い程、計測精度が向上します。左記画像の場合、単純モノクロより、G成分抽出モノクロ化の選択で計測精度を上げることができます。
[ 機能紹介 ]
・重なり分離機能
コロニーが重なっていても、自動的に分離して個数計測
・スパイラルコロニー計測機能
エリアを自由に変更でき、あらゆるスパイラルプレータに対応

・大きさによる選択機能
大きさによる選択機能により広がったコロニーを除去カウント可能

・円形度による選択機能(標準モード)
線状のゴミ・傷を取り除いたり、特定コロニー選択可能

・明るさムラ補正機能(標準モード)
培地の厚みにムラがある検体でも厚みムラによる輝度を補正し、高精度な計測が可能
・4色抽出分離計測機能(標準モード)
コロニーの色の違いにより、最大4種類まで分離計測可能

主な仕様
| 型式 | PSF-3000 PSF-2000 |
| 本体寸法 | 約W280×D320×H620 |
| 重量 | 本体 約17Kg |
| 電源AC100V | 50/60Hz |
| システム構成 | 本体、データ - 処理用デスクトップパソコン、17 インチモニタ |
| 動作環境 | 温度 10℃〜35℃、湿度 20%〜80% |
| カメラ分解能 | 150万画素 CCD |
| カメラ仕様 | カラー仕様 |
| 計測対象 | シャーレ上の生菌コロニー |
| シャーレサイズ | 90mmφシャーレ以下 |
| 計測サイズ | 0.1mm/90mm 視野 |
| 計測時間 | 約1〜3秒/1シャーレ |
| 最大カウント数 | 生菌コロニー:約8000個 |
| 照明手法 | 暗視野、明視野、ドーム側光、上部側光 |




